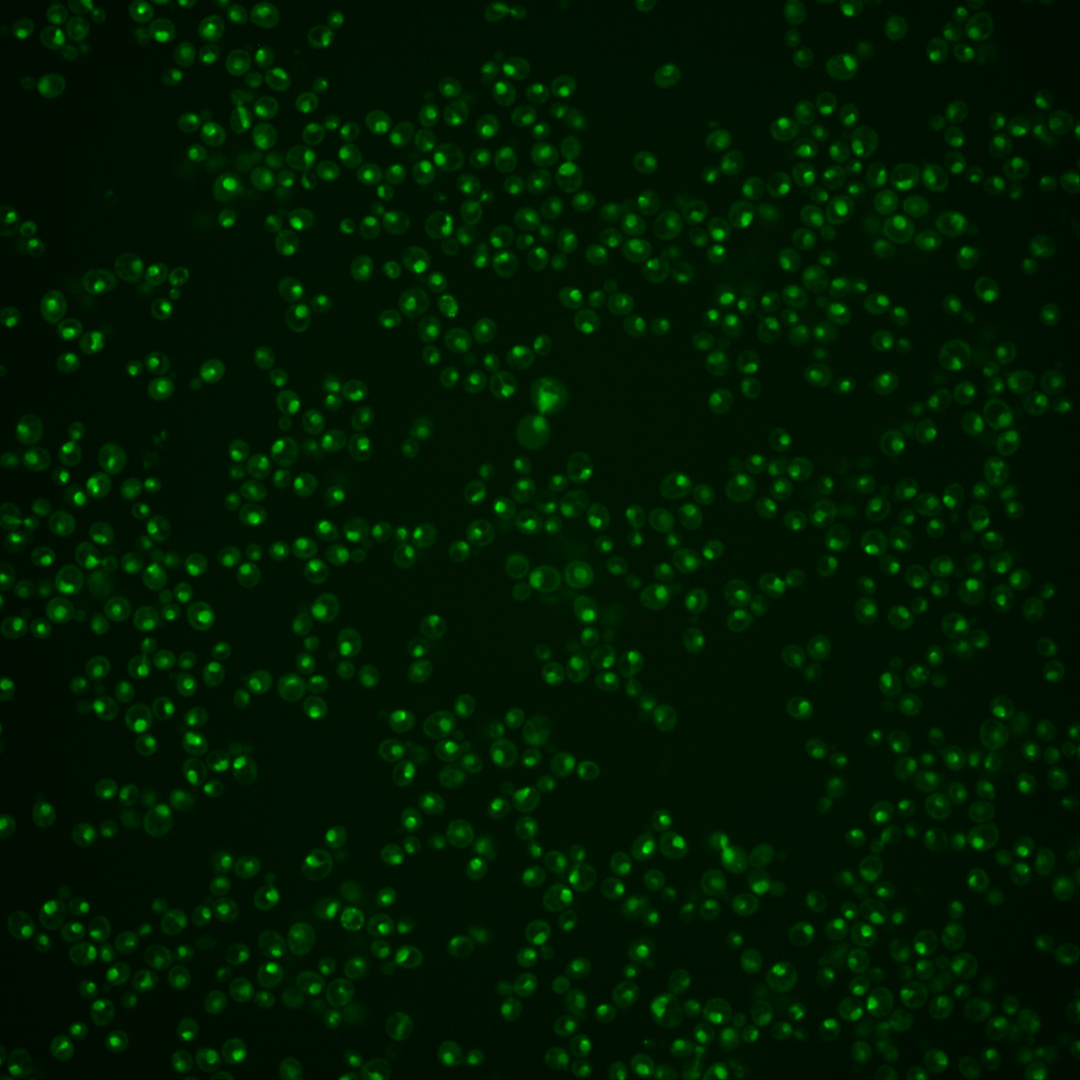
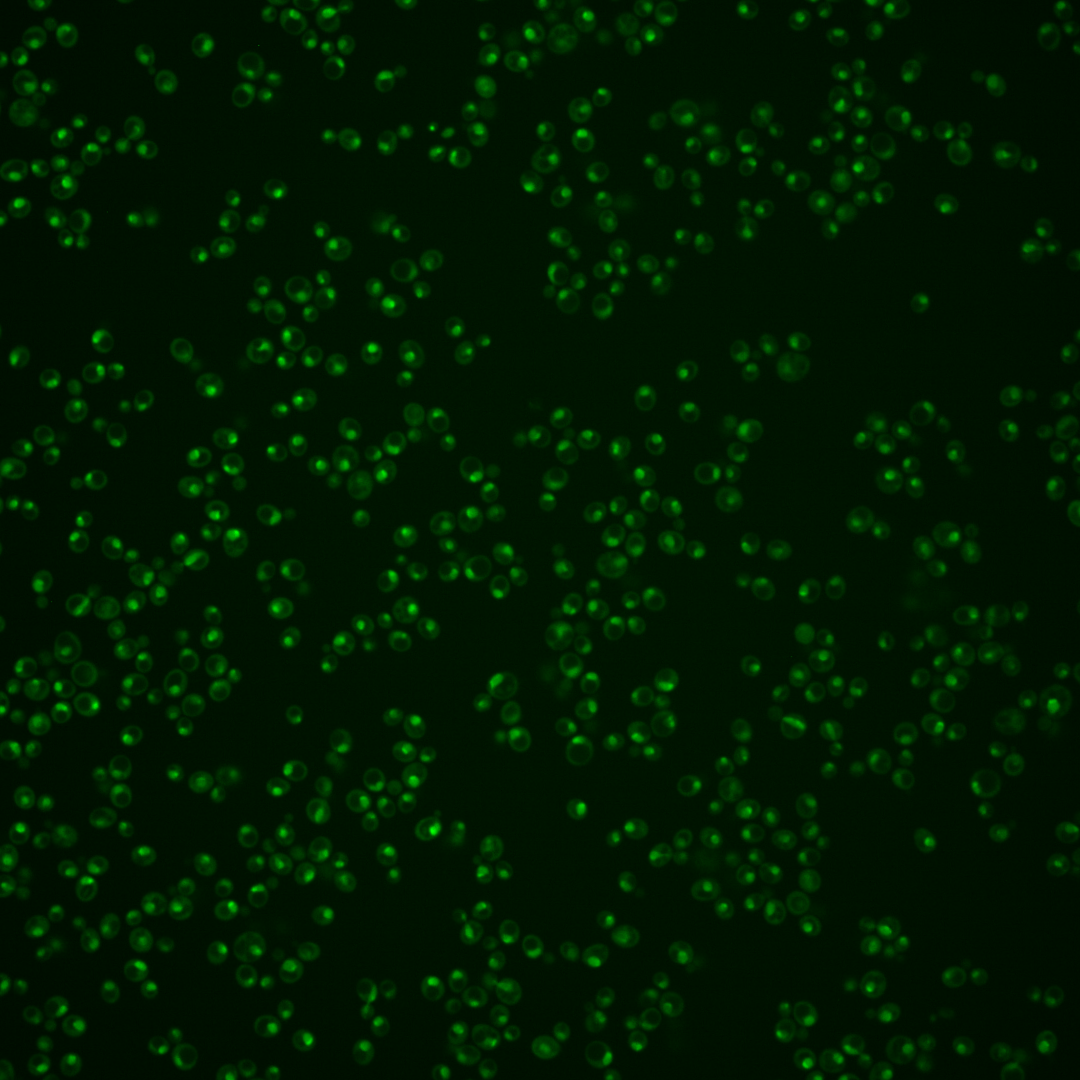
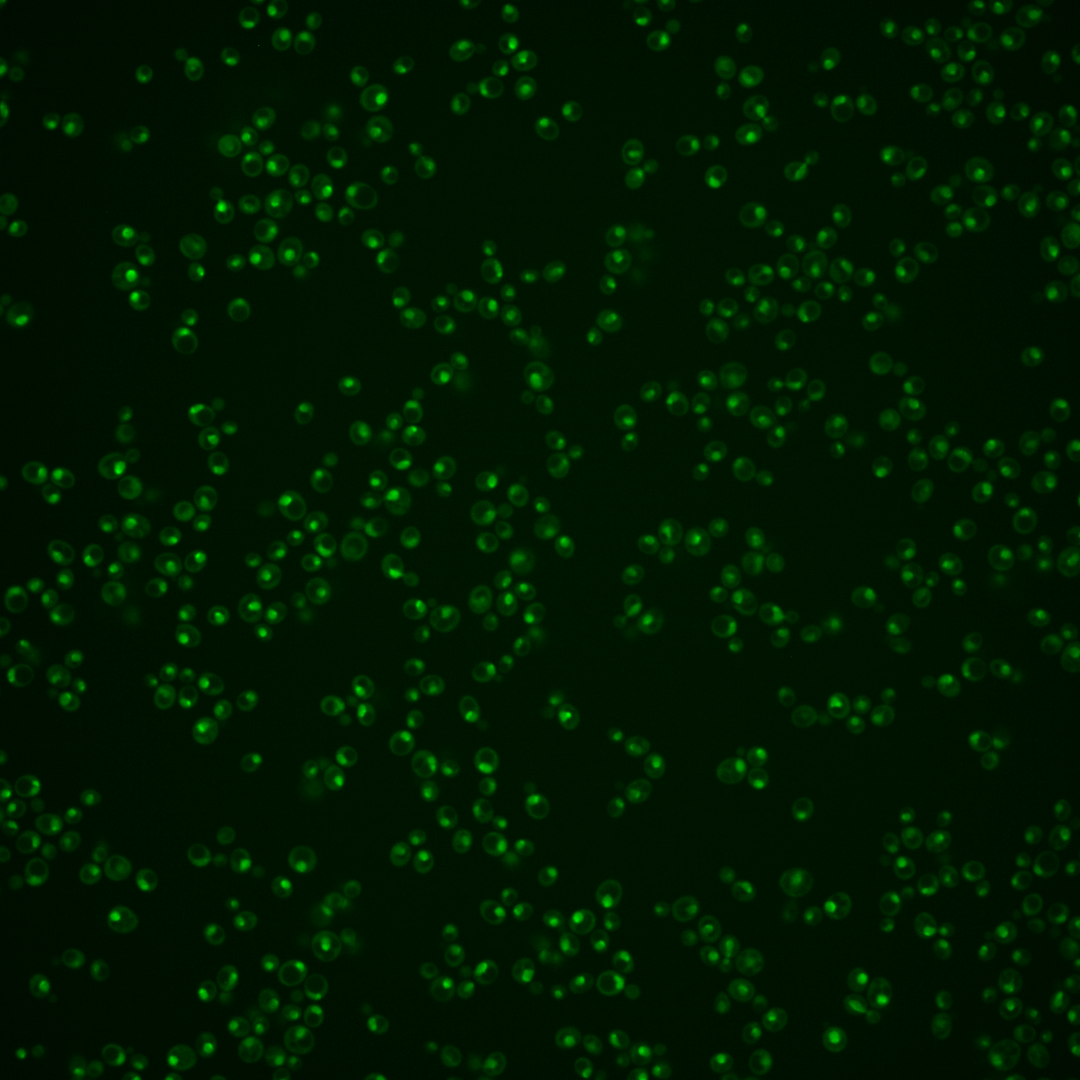

| Standard name | |
|---|---|
| Human Ortholog | |
| Description | Nuclear dsRNA-specific ribonuclease (RNase III); involved in rDNA transcription, rRNA processing and U2 snRNA 3' end formation by cleavage of a stem-loop structure at the 3' end of U2 snRNA; involved in polyadenylation-independent transcription termination; involved in the cell wall stress response, regulating the degradation of cell wall integrity and morphogenesis checkpoint genes |
Micrographs




















































































Sub-cellular Localization
Yeast GFP Assignment
Protein Abundance
Localization Change
External localization resources
| ensLOC | DeepLoc | |||||||||||||||||||||||
|---|---|---|---|---|---|---|---|---|---|---|---|---|---|---|---|---|---|---|---|---|---|---|---|---|
| Localization | WT1 | WT2 | WT3 | RAP60 | RAP140 | RAP220 | RAP300 | RAP380 | RAP460 | RAP540 | RAP620 | RAP700 | HU80 | HU120 | HU160 | rpd3Δ_1 | rpd3Δ_2 | rpd3Δ_3 | WT1 | WT2 | WT3 | AF100 | AF140 | AF180 |
| Cortical Patches | 0 | 0 | 0 | 0 | 0 | 0 | 0 | 0 | 0 | 0 | 0 | 0 | 0 | 0 | 0 | 0 | 0 | 0 | 0 | 0 | 0 | 0 | 0 | 0 |
| Bud | 0 | 0 | 0 | 0 | 0 | 0 | 1 | 1 | 2 | 1 | 0 | 0 | 0 | 0 | 0 | 1 | 0 | 0 | 1 | 0 | 0 | 1 | 2 | 3 |
| Bud Neck | 0 | 0 | 0 | 0 | 0 | 0 | 0 | 0 | 0 | 0 | 0 | 0 | 0 | 0 | 0 | 0 | 0 | 0 | 0 | 0 | 0 | 0 | 0 | 1 |
| Bud Site | 0 | 0 | 0 | 0 | 1 | 1 | 1 | 1 | 2 | 0 | 4 | 7 | 1 | 0 | 0 | 0 | 0 | 0 | – | – | – | – | – | – |
| Cell Periphery | 0 | 0 | 0 | 0 | 0 | 0 | 0 | 0 | 0 | 0 | 0 | 0 | 0 | 0 | 0 | 0 | 0 | 0 | 0 | 0 | 0 | 0 | 0 | 0 |
| Cytoplasm | 2 | 1 | 0 | 4 | 2 | 14 | 11 | 21 | 10 | 12 | 7 | 7 | 23 | 40 | 41 | 26 | 23 | 14 | 1 | 1 | 0 | 3 | 0 | 2 |
| Endoplasmic Reticulum | 0 | 0 | 0 | 0 | 0 | 0 | 0 | 0 | 0 | 0 | 0 | 0 | 0 | 1 | 0 | 10 | 8 | 7 | 0 | 0 | 0 | 1 | 1 | 2 |
| Endosome | 0 | 0 | 0 | 0 | 0 | 1 | 1 | 1 | 0 | 0 | 0 | 0 | 5 | 14 | 15 | 5 | 8 | 2 | 2 | 1 | 2 | 3 | 16 | 16 |
| Golgi | 0 | 0 | 0 | 0 | 0 | 0 | 0 | 0 | 0 | 0 | 0 | 0 | 0 | 0 | 0 | 2 | 0 | 0 | 0 | 0 | 0 | 1 | 1 | 1 |
| Mitochondria | 7 | 2 | 5 | 20 | 6 | 19 | 56 | 71 | 48 | 37 | 71 | 61 | 6 | 9 | 3 | 14 | 6 | 6 | 0 | 2 | 1 | 2 | 7 | 13 |
| Nucleus | 128 | 99 | 21 | 41 | 20 | 45 | 31 | 67 | 43 | 33 | 53 | 44 | 116 | 98 | 112 | 274 | 251 | 160 | 101 | 89 | 24 | 63 | 59 | 56 |
| Nuclear Periphery | 2 | 0 | 0 | 0 | 1 | 0 | 4 | 1 | 2 | 5 | 2 | 3 | 1 | 4 | 1 | 4 | 5 | 0 | 0 | 1 | 0 | 1 | 5 | 8 |
| Nucleolus | 46 | 29 | 22 | 50 | 18 | 29 | 31 | 41 | 24 | 19 | 31 | 27 | 177 | 183 | 210 | 152 | 105 | 85 | 57 | 41 | 29 | 80 | 95 | 87 |
| Peroxisomes | 0 | 0 | 0 | 0 | 0 | 0 | 0 | 0 | 0 | 0 | 0 | 0 | 0 | 5 | 6 | 0 | 0 | 0 | 0 | 0 | 0 | 0 | 0 | 0 |
| SpindlePole | 0 | 0 | 0 | 2 | 1 | 0 | 1 | 7 | 0 | 1 | 1 | 1 | 3 | 10 | 10 | 6 | 6 | 4 | 0 | 0 | 2 | 4 | 13 | 8 |
| Vac/Vac Membrane | 3 | 4 | 1 | 2 | 1 | 2 | 2 | 7 | 2 | 1 | 0 | 6 | 1 | 7 | 8 | 21 | 34 | 12 | 5 | 7 | 4 | 29 | 60 | 73 |
| Unique Cell Count | 163 | 125 | 41 | 80 | 39 | 89 | 95 | 160 | 89 | 78 | 116 | 111 | 295 | 318 | 356 | 451 | 405 | 264 | 172 | 147 | 66 | 196 | 271 | 280 |
| Labelled Cell Count | 188 | 135 | 49 | 119 | 50 | 111 | 139 | 218 | 133 | 109 | 169 | 156 | 333 | 371 | 406 | 515 | 446 | 290 | 172 | 147 | 66 | 196 | 271 | 280 |
Yeast GFP Assignment
Protein Abundance
| Screen | WT1 | WT2 | WT3 | RAP60 | RAP140 | RAP220 | RAP300 | RAP380 | RAP460 | RAP540 | RAP620 | RAP700 | HU80 | HU120 | HU160 | rpd3Δ_1 | rpd3Δ_2 | rpd3Δ_3 | AF100 | AF140 | AF180 |
|---|---|---|---|---|---|---|---|---|---|---|---|---|---|---|---|---|---|---|---|---|---|
| Mean Cell GFP Intensity (1e-4) | 8.3 | 9.6 | 6.8 | 6.4 | 5.6 | 5.7 | 4.3 | 5.0 | 4.6 | 4.6 | 4.4 | 4.7 | 8.3 | 7.8 | 7.7 | 10.6 | 12.2 | 12.1 | 7.3 | 7.6 | 8.1 |
| Std Deviation (1e-4) | 1.4 | 2.2 | 1.5 | 1.6 | 1.3 | 1.4 | 1.2 | 1.6 | 1.0 | 1.6 | 1.2 | 1.7 | 2.1 | 2.2 | 2.0 | 4.3 | 4.0 | 4.7 | 1.3 | 1.5 | 1.4 |
| Intensity Change (Log2) | – | – | – | -0.07 | -0.28 | -0.25 | -0.65 | -0.45 | -0.55 | -0.57 | -0.61 | -0.51 | 0.3 | 0.21 | 0.18 | 0.65 | 0.85 | 0.84 | 0.11 | 0.17 | 0.27 |
Localization Change
| Localization | RAP60 | RAP140 | RAP220 | RAP300 | RAP380 | RAP460 | RAP540 | RAP620 | RAP700 | HU80 | HU120 | HU160 | rpd3Δ_1 | rpd3Δ_2 | rpd3Δ_3 |
|---|---|---|---|---|---|---|---|---|---|---|---|---|---|---|---|
| Cortical Patches | 0 | 0 | 0 | 0 | 0 | 0 | 0 | 0 | 0 | 0 | 0 | 0 | 0 | 0 | 0 |
| Bud | 0 | 0 | 0 | 0 | 0 | 0 | 0 | 0 | 0 | 0 | 0 | 0 | 0 | 0 | 0 |
| Bud Neck | 0 | 0 | 0 | 0 | 0 | 0 | 0 | 0 | 0 | 0 | 0 | 0 | 0 | 0 | 0 |
| Bud Site | 0 | 0 | 0 | 0 | 0 | 0 | 0 | 0 | 0 | 0 | 0 | 0 | 0 | 0 | 0 |
| Cell Periphery | 0 | 0 | 0 | 0 | 0 | 0 | 0 | 0 | 0 | 0 | 0 | 0 | 0 | 0 | 0 |
| Cytoplasm | 0 | 0 | 0 | 0 | 0 | 0 | 0 | 0 | 0 | 0 | 0 | 0 | 0 | 0 | 0 |
| Endoplasmic Reticulum | 0 | 0 | 0 | 0 | 0 | 0 | 0 | 0 | 0 | 0 | 0 | 0 | 0 | 0 | 0 |
| Endosome | 0 | 0 | 0 | 0 | 0 | 0 | 0 | 0 | 0 | 0 | 0 | 0 | 0 | 0 | 0 |
| Golgi | 0 | 0 | 0 | 0 | 0 | 0 | 0 | 0 | 0 | 0 | 0 | 0 | 0 | 0 | 0 |
| Mitochondria | 1.6 | 0.4 | 1.2 | 0 | 3.8 | 0 | 0 | 0 | 0 | 0 | 0 | 0 | 0 | 0 | 0 |
| Nucleus | 0 | 0 | -0.1 | -2.0 | -1.1 | -0.3 | -0.9 | -0.6 | -1.3 | -1.5 | -2.6 | -2.5 | 1.2 | 1.3 | 1.1 |
| Nuclear Periphery | 0 | 0 | 0 | 0 | 0 | 0 | 0 | 0 | 0 | 0 | 0 | 0 | 0 | 0 | 0 |
| Nucleolus | 0.9 | -0.7 | -2.3 | 0 | -3.5 | 0 | 0 | 0 | 0 | 0.8 | 0.5 | 0.7 | -2.6 | -3.7 | -2.7 |
| Peroxisomes | 0 | 0 | 0 | 0 | 0 | 0 | 0 | 0 | 0 | 0 | 0 | 0 | 0 | 0 | 0 |
| SpindlePole | 0 | 0 | 0 | 0 | 0 | 0 | 0 | 0 | 0 | 0 | 0 | 0 | 0 | 0 | 0 |
| Vacuole | 0 | 0 | 0 | 0 | 0 | 0 | 0 | 0 | 0 | 0 | 0 | 0 | 0 | 0 | 0 |
External localization resources
Images






























Protein Concentration and Protein Localization Data
| R1 | R2 | R3 | ||||||||||||||||
|---|---|---|---|---|---|---|---|---|---|---|---|---|---|---|---|---|---|---|
| G1 Pre-START | G1 Post-START | S/G2 | Metaphase | Anaphase | Telophase | G1 Pre-START | G1 Post-START | S/G2 | Metaphase | Anaphase | Telophase | G1 Pre-START | G1 Post-START | S/G2 | Metaphase | Anaphase | Telophase | |
| Concentration | 6.2938 | 6.7659 | 6.4364 | 8.648 | 6.6831 | 6.2502 | 6.5236 | 6.2242 | 6.3522 | 6.04 | 5.8078 | 6.2308 | 7.241 | 7.7248 | 7.4021 | 6.9543 | 6.9799 | 7.0237 |
| Actin | 0.0006 | 0 | 0 | 0 | 0.0023 | 0 | 0.0016 | 0.0001 | 0.0003 | 0 | 0 | 0.0001 | 0.0027 | 0 | 0.0001 | 0 | 0.0027 | 0 |
| Bud | 0.0001 | 0 | 0 | 0 | 0.0001 | 0.0001 | 0.0001 | 0 | 0.0005 | 0 | 0 | 0 | 0.0001 | 0 | 0 | 0 | 0.0003 | 0 |
| Bud Neck | 0.0004 | 0.0003 | 0.0002 | 0.0001 | 0.0004 | 0.0007 | 0.0004 | 0.0002 | 0.0003 | 0.0002 | 0.001 | 0.0007 | 0.0004 | 0.0002 | 0.0002 | 0.0004 | 0.0134 | 0.001 |
| Bud Periphery | 0.0002 | 0 | 0 | 0 | 0.0002 | 0.0001 | 0.0003 | 0.0001 | 0.0003 | 0 | 0.0001 | 0.0001 | 0.0003 | 0 | 0.0001 | 0.0001 | 0.0006 | 0.0001 |
| Bud Site | 0.0002 | 0.0001 | 0.0001 | 0 | 0.0003 | 0.0001 | 0.0007 | 0.0002 | 0.0003 | 0.0001 | 0.0001 | 0.0001 | 0.0003 | 0.0001 | 0.0001 | 0.0001 | 0.0034 | 0.0001 |
| Cell Periphery | 0.0001 | 0 | 0.0001 | 0 | 0 | 0 | 0.0001 | 0.0001 | 0.0001 | 0 | 0 | 0.0001 | 0.0001 | 0 | 0 | 0 | 0.0002 | 0.0001 |
| Cytoplasm | 0.0002 | 0 | 0 | 0 | 0.0005 | 0.0001 | 0.0007 | 0.0001 | 0.0006 | 0 | 0 | 0.0001 | 0.0003 | 0.0004 | 0.0001 | 0 | 0.0003 | 0 |
| Cytoplasmic Foci | 0.0008 | 0 | 0 | 0 | 0.0039 | 0 | 0.0061 | 0.0001 | 0.003 | 0 | 0 | 0.0001 | 0.0004 | 0 | 0.0003 | 0 | 0.001 | 0 |
| Eisosomes | 0 | 0 | 0 | 0 | 0 | 0 | 0 | 0.0002 | 0 | 0 | 0 | 0 | 0 | 0 | 0 | 0 | 0.0001 | 0 |
| Endoplasmic Reticulum | 0.0002 | 0 | 0 | 0 | 0.0004 | 0.0001 | 0.0004 | 0 | 0.0004 | 0 | 0 | 0.0001 | 0.0006 | 0.0001 | 0.0001 | 0 | 0.0006 | 0 |
| Endosome | 0.0012 | 0 | 0 | 0 | 0.0037 | 0.0006 | 0.0053 | 0.0002 | 0.0008 | 0 | 0 | 0.0004 | 0.0018 | 0.0002 | 0.0003 | 0.0001 | 0.0077 | 0 |
| Golgi | 0.0002 | 0 | 0 | 0 | 0.0011 | 0 | 0.0011 | 0 | 0.0002 | 0 | 0 | 0.0001 | 0.0005 | 0 | 0.0001 | 0 | 0.0018 | 0 |
| Lipid Particles | 0.0012 | 0 | 0 | 0 | 0.0027 | 0.0001 | 0.0047 | 0.0004 | 0.002 | 0 | 0.0001 | 0.0006 | 0.0015 | 0 | 0.0016 | 0.0001 | 0.003 | 0.0001 |
| Mitochondria | 0.001 | 0.0001 | 0.0001 | 0 | 0.0005 | 0.0002 | 0.0027 | 0.0001 | 0.0005 | 0 | 0.0002 | 0.0006 | 0.0017 | 0.0001 | 0.0002 | 0.0002 | 0.0031 | 0.0001 |
| None | 0.0002 | 0 | 0 | 0 | 0.0005 | 0 | 0.0017 | 0.006 | 0.0006 | 0 | 0 | 0 | 0.0006 | 0 | 0.0001 | 0 | 0.0006 | 0 |
| Nuclear Periphery | 0.0019 | 0.0104 | 0.0005 | 0.0003 | 0.0039 | 0.0048 | 0.0026 | 0.0062 | 0.005 | 0.0001 | 0.0021 | 0.0016 | 0.0026 | 0.001 | 0.004 | 0.0177 | 0.0019 | 0.0007 |
| Nucleolus | 0.4621 | 0.3989 | 0.5329 | 0.4856 | 0.5251 | 0.554 | 0.4948 | 0.5045 | 0.5882 | 0.5784 | 0.527 | 0.6104 | 0.4852 | 0.4435 | 0.5308 | 0.5268 | 0.4721 | 0.5844 |
| Nucleus | 0.5196 | 0.5836 | 0.4602 | 0.5101 | 0.4396 | 0.4356 | 0.4595 | 0.4698 | 0.3864 | 0.42 | 0.4579 | 0.3771 | 0.4926 | 0.5504 | 0.4468 | 0.4495 | 0.469 | 0.4035 |
| Peroxisomes | 0.0034 | 0 | 0 | 0 | 0.0011 | 0 | 0.0046 | 0 | 0.0013 | 0 | 0 | 0.0001 | 0.0003 | 0 | 0 | 0 | 0.0008 | 0 |
| Punctate Nuclear | 0.0044 | 0.0052 | 0.0056 | 0.0037 | 0.013 | 0.0023 | 0.0108 | 0.0108 | 0.0081 | 0.0011 | 0.0111 | 0.0068 | 0.0068 | 0.0033 | 0.0147 | 0.0044 | 0.0151 | 0.0095 |
| Vacuole | 0.0012 | 0.0002 | 0.0002 | 0 | 0.0005 | 0.0008 | 0.0011 | 0.0006 | 0.0006 | 0.0001 | 0.0001 | 0.0006 | 0.0006 | 0.0005 | 0.0003 | 0.0002 | 0.0017 | 0.0002 |
| Vacuole Periphery | 0.0006 | 0.001 | 0.0001 | 0 | 0.0003 | 0.0004 | 0.0007 | 0.0003 | 0.0004 | 0 | 0.0001 | 0.0002 | 0.0005 | 0.0001 | 0.0002 | 0.0003 | 0.0007 | 0.0001 |
Sequencing Data
| R1 | R2 | |||||||||
|---|---|---|---|---|---|---|---|---|---|---|
| G1 Post-START | S/G2 | Metaphase | Anaphase | Telophase | G1 Post-START | S/G2 | Metaphase | Anaphase | Telophase | |
| Gene Expression | 30.3904 | 17.4148 | 18.6085 | 17.2919 | 16.1651 | 14.0186 | 11.6214 | 12.5974 | 10.7941 | 18.3527 |
| Translational Efficiency | 1.0615 | 1.2276 | 1.0279 | 0.8334 | 1.1069 | 1.3554 | 1.017 | 0.6623 | 0.6914 | 0.787 |
Hit Data
| Dataset | Hit |
|---|---|
| Protein Concentration | ✘ |
| Protein Localization | ✘ |
| Gene Expression | ✘ |
| Translational Efficiency | ✘ |
Endocytosis
| Temp | Actin Patch (Sac6-tdTomato) | Cortical Patch (Sla1-GFP) | Late Endosome (Snf7-GFP) | Vacuole (Vph1-GFP) |
|---|---|---|---|---|
| 37℃ | ||||
| RT |
Cell Cycle Omics
CYCLoPs (Rnt1-GFP)
| Gene / Allele | Actin Patch (Sac6-tdTomato) | Cortical Patch (Sla1-GFP) | Late Endosome (Snf7-GFP) | Vacuole (Sac6-tdTomato) |
|---|
| Gene | Images |
|---|
| Gene | Images |
|---|
Images are not yet available
Images are not yet available